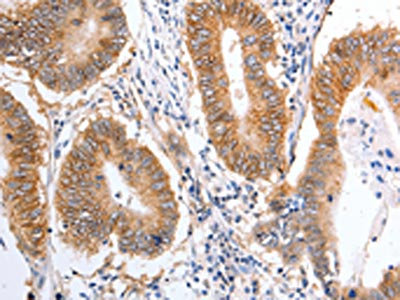

-
中文名稱:PIWIL1兔多克隆抗體
-
貨號:CSB-PA176370
-
規格:¥1100
-
圖片:
-
The image on the left is immunohistochemistry of paraffin-embedded Human colon cancer tissue using CSB-PA176370(PIWIL1 Antibody) at dilution 1/25, on the right is treated with fusion protein. (Original magnification: ×200)
-
The image on the left is immunohistochemistry of paraffin-embedded Human ovarian cancer tissue using CSB-PA176370(PIWIL1 Antibody) at dilution 1/25, on the right is treated with fusion protein. (Original magnification: ×200)
-
-
其他:
產品詳情
-
Uniprot No.:
-
基因名:
-
別名:HIWI antibody; MIWI antibody; Piwi (Drosophila) like 1 antibody; PIWI antibody; Piwi homolog antibody; Piwi like 1 (drosophila) antibody; Piwi like 1 antibody; Piwi-like protein 1 antibody; PIWIL1 antibody; PIWL1_HUMAN antibody
-
宿主:Rabbit
-
反應種屬:Human,Mouse
-
免疫原:Fusion protein of Human PIWIL1
-
免疫原種屬:Homo sapiens (Human)
-
標記方式:Non-conjugated
-
抗體亞型:IgG
-
純化方式:Antigen affinity purification
-
濃度:It differs from different batches. Please contact us to confirm it.
-
保存緩沖液:-20°C, pH7.4 PBS, 0.05% NaN3, 40% Glycerol
-
產品提供形式:Liquid
-
應用范圍:ELISA,IHC
-
推薦稀釋比:
Application Recommended Dilution ELISA 1:1000-1:5000 IHC 1:25-1:100 -
Protocols:
-
儲存條件:Upon receipt, store at -20°C or -80°C. Avoid repeated freeze.
-
貨期:Basically, we can dispatch the products out in 1-3 working days after receiving your orders. Delivery time maybe differs from different purchasing way or location, please kindly consult your local distributors for specific delivery time.
-
用途:For Research Use Only. Not for use in diagnostic or therapeutic procedures.
相關產品
靶點詳情
-
功能:Endoribonuclease that plays a central role in postnatal germ cells by repressing transposable elements and preventing their mobilization, which is essential for the germline integrity. Acts via the piRNA metabolic process, which mediates the repression of transposable elements during meiosis by forming complexes composed of piRNAs and Piwi proteins and governs the methylation and subsequent repression of transposons. Directly binds methylated piRNAs, a class of 24 to 30 nucleotide RNAs that are generated by a Dicer-independent mechanism and are primarily derived from transposons and other repeated sequence elements. Strongly prefers a uridine in the first position of their guide (g1U preference, also named 1U-bias). Not involved in the piRNA amplification loop, also named ping-pong amplification cycle. Acts as an endoribonuclease that cleaves transposon messenger RNAs. Besides their function in transposable elements repression, piRNAs are probably involved in other processes during meiosis such as translation regulation. Probable component of some RISC complex, which mediates RNA cleavage and translational silencing. Also plays a role in the formation of chromatoid bodies and is required for some miRNAs stability. Required to sequester RNF8 in the cytoplasm until late spermatogenesis; RNF8 being released upon ubiquitination and degradation of PIWIL1.; May be a negative developmental regulator.
-
基因功能參考文獻:
- piRNAs may function in gene silencing and gene modification upstream or downstream of oncogenes in cancer cell lines or cancer tissues. In addition to piRNAs, PIWI proteins can be used as biomarkers for prognosis, diagnosis and clinical evaluation and may be factors in cancer metastasis. PMID: 30226604
- Unlike most other Tudor domains TDRD2 preferentially recognizes an unmethylated arginine-rich sequence from PIWIL1. PMID: 29118143
- HENMT1 and PIWI proteins are expressed in a germ-cell-specific manner and required for transposon control. PMID: 28676534
- A statistically significantly higher level of PIWIL1 and PIWIL2 was found in IDC compared to mastopathy samples (pPMID: 29599319
- Expression of PIWIL1 in the cancer tissue was higher than that in the corresponding adjacent tissue. High PIWIL1 expression suggests a poor prognosis for colorectal cancer patients. PMID: 28634417
- PIWIL3 and PIWIL4 genes showed prognostic relevance. 306 gene targets exhibited reciprocal relationship with piRNA expression PMID: 27177224
- Findings identify Piwi as a factor in human infertility and reveal its role in regulating the histone-to-protamine exchange during spermiogenesis. PMID: 28552346
- In blood serum, piR-823 is up-regulated, but with unsatisfactory analytical performance. Preliminary data indicate the promising diagnostic utility of urinary piR-823 in patients with RCC PMID: 27919963
- Overexpression of Hiwi significantly suppressed cell proliferation and cell migration and induced apoptosis in K562 cells. PMID: 25701408
- Hiwi upregulation enhanced chemosensitivity of Chronic Myeloid Leukemia cells to daunomycin, suppressed cell proliferation and promoted apoptosis. PMID: 25701955
- HIWI promotes the activity of breast cancer cells while depression of HIWI may induce apoptosis of breast cancer cells. PMID: 26847393
- Our study reveals a novel mechanism for PIWIL1 in tumorigenesis. PMID: 26317901
- PIWIL1 expression emerged as an independent prognostic marker in non-small cell lung cancer. PMID: 25742785
- Among patients with high let-7a expression, those with medium HIWI had an increased risk of death compared to those with low HIWI (HR = 2.62, 95% CI: 1.30-5.30). PMID: 25630839
- results suggested that Piwil1 caused the loss of PTEN expression through DNMT1-mediated PTEN hypermethylation PMID: 26056945
- Results show that HIWI is highly expressed in high-grade squamous intraepithelial lesions and cervical cancer tissues suggesting its participation in the carcinogenesis of cervical cancer. PMID: 25119492
- Our results indicate a reciprocal regulation between HIWI, HILI and some CSCs markers in colorectal cancer PMID: 26026091
- Evidence of an active PIWI-interacting small non-coding RNAs pathway in BC suggests that these small non-coding RNAs do exert transcriptional and post-transcriptional gene regulatory actions also in cancer cells. PMID: 25313140
- Hiwi downregulation mediated by shRNA reduce the proliferation and migration of HCC cells. PMID: 25370791
- These findings suggest that HIWI is an oncogene involved in the progression of glioma. PMID: 25269862
- Overexpression of hiwi promotes growth of breast cancer cells. PMID: 25292027
- IGFBP-5 may be a negative modulator of RASSF1C/ PIWIL1 growth-promoting activities. PMID: 25007054
- A important role of HIWI and DPPA2 in tumorigenesis and also in lymph node metastasis of tumor cells. PMID: 24532429
- detection of mitochondrial Piwi by colocalization using anti-Piwil1 and mitochondria organelle-specific protein antibodies in cancer cell lines PMID: 24602614
- Our study identifies surrogate DNA methylation markers for idiopathic infertility in peripheral blood and suggests that allele-specific DNA methylation differences at regulatory sites of genes are associated with disturbed spermatogenesis. PMID: 24524831
- associations were determined between the Piwi-like family member expression levels and clinicopathological parameters of ccRCC, suggesting a potential role for these genes/proteins in ccRCC diagnostics and tumorigenesis PMID: 24509249
- Polymorphism in PIWIL1 gene is associated with HBV-related hepatocellular carcinoma PMID: 23868705
- Findings suggest the role of RASSF1C/PIWIL1 proteins in initiation and progression of lung cancer. PMID: 22591718
- Expression of PIWIL1 was an independent prognostic factor in gastric cancer. PMID: 22670175
- Hiwi-associated DNA hyper-methylation with subsequent genetic and epigenetic changes favors a tumorigenic state PMID: 22438986
- HIWI may play a key role in hepatocellular carcinoma (HCC) proliferation and metastasis and can be a potential prognostic factor for HCC after curative resection PMID: 21989785
- A subgroup of more aggressive tumors can be identified by evaluating Hiwi level in lymph node metastatic cancer. PMID: 22261620
- Colorectal cancer patients with positive HIWI expression in adjacent non-cancerous tissue had statistically lower overall survival (OS) and disease free survival (DFS) compared with negative patients. PMID: 21933617
- In this review, the current state of knowledge on the structure, biogenesis and function of piRNA and their interactions with Piwi proteins is presented. PMID: 22235650
- HIWI expression is significantly higher in HCC tissue than in adjacent normal hepatic tissue. PMID: 21327579
- The human piwi-like 1 PAZ domain is a typical OB fold and specifically recognizes the 2nt 3 0 -OH end of the single-stranded RNA and buries the two 3 0 -terminal nucleotides in the hydrophobic cleft. PMID: 21465557
- The result of this study suggested that Hiwi may be a critical factor in glioma progression and could be used as a potential molecular marker for pathological diagnosis and prognosis evaluation for malignant gliomas. PMID: 21138738
- These results suggest that hiwi plays an important role in the oncogenesis and is a potential target for cancer angiogenesis PMID: 20204292
- The expression of HIWI in the cytoplasm of esophageal cancer cells is significantly associated with higher histological grade, clinical stage and poorer clinical outcome PMID: 19995427
- specifically expressed in both normal and malignant spermatogenic cells in a maturation stage-dependent pattern, in which it might function in germ cell proliferation PMID: 12037681
- results suggest that hiwi may be involved in the development of gastric cancer and is a potential target for cancer therapy PMID: 16287078
- High-level expression of Hiwi mRNA identifies soft-tissue sarcoma patients at high risk of tumor-related death. PMID: 16953229
- alterations in mRNA expression of Hiwi can increase the risk of tumour-related death in male ductal pancreatic carcinoma patients PMID: 18781170
顯示更多
收起更多
-
相關疾病:Defects in PIWIL1 may be a cause of a disorder resulting in the absence of sperm (azoospermia) in the semen, leading to male infertility. Male sterility can be caused by defects in ubiquitination and degradation during late spermatogenesis.
-
亞細胞定位:Cytoplasm.
-
蛋白家族:Argonaute family, Piwi subfamily
-
組織特異性:Expressed in spermatocytes and spermatids. Also detected in prostate cancer (at protein level). Detected in most fetal and adult tissues. Expressed in testes, specifically in germline cells; detected in spermatocytes and spermatids during spermatogenesis.
-
數據庫鏈接:
Most popular with customers
-
-
YWHAB Recombinant Monoclonal Antibody
Applications: ELISA, WB, IHC, IF, FC
Species Reactivity: Human, Mouse, Rat
-
Phospho-YAP1 (S127) Recombinant Monoclonal Antibody
Applications: ELISA, WB, IHC
Species Reactivity: Human
-
-
-
-
-